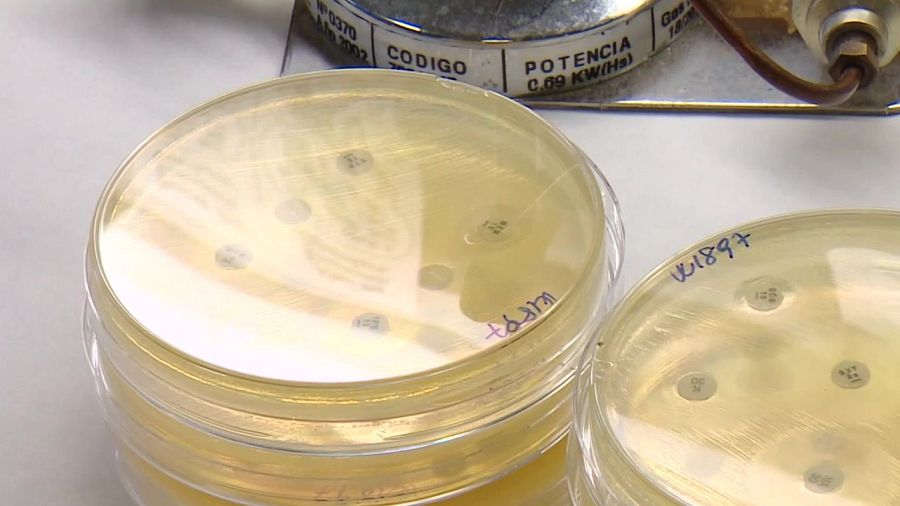

Conocemos el día a día de las personas con la enfermedad de Parkinson
- En La Rioja hay 2.200 personas diagnosticadas de Parkinson, aunque muchas más podrían padecer la enfermedad sin saberlo
- La Asociación de Parkinson de La Rioja cuenta con unos 60 socios y en torno a unos 25 acuden a su sede a diario
La Asociación de Parkinson de La Rioja cuenta con unos 60 socios y en torno a unos 25 acuden a su sede a diario. A algunos les costó dar el paso, porque para muchos enfermos el diagnóstico cae como un jarro de agua fría.
Pero una vez tienen el diagnóstico, la entidad es un estímulo para ellos y un refugio emocional, ya que allí se encuentran a personas en su misma situación y se dan cuenta de que no solo les sucede a ellos.

Conocemos el día a día de las personas con la enfermedad del Parkinson RTVE LA RIOJA
Para mejorar su salud física a la vez que se entretienen, se organizan actividades como clases de salsa, talleres, musicología o taichi.
También sesiones con profesionales especializados como logopedas, psicólogos o fisioterapeutas. Estos últimos son esenciales para prevenir lesiones, evitar el avance de la enfermedad y ganar calidad de vida.

Conocemos el día a día de las personas con la enfermedad del Parkinson RTVE LA RIOJA
Los usuarios reclaman un diagnostico más rápido para poder frenar el avance de los síntomas.
Qué es el Parkinson
El Parkinson es la segunda enfermedad neurodegenerativa más frecuente e implica la pérdida de grupos de neuronas en el cerebro. La causa en la mayoría de los casos es desconocida porque puede darse debido a muchos factores como el envejecimiento o factores ambientales o genéticos, por lo que cada paciente es único.
Las nuevas investigaciones
Una línea de investigación del CIBIR estudia los mecanismos moleculares responsables de las enfermedades neurodegenerativas con un foco prioritario en la neuro inflamación. Los expertos dicen que cada vez hay más evidencia de que esta neuro inflamación no solo es consecuencia de la muerte neuronal, sino que también es uno de los desencadenantes de la enfermedad. Por eso, al estudiar en profundidad por qué se produce, pueden averiguar nuevos biomarcadores tempranos y nuevos tratamientos.
Las nuevas investigaciones RTVE LA RIOJA
La ciencia requiere tiempo, recursos y una inversión estable para tener avances reales. Ahora se están dando los primeros resultados en modelos animales pero aún queda un largo camino. Prevén que en una década ya podría haber tratamientos que sean capaces de cambiar el curso de la enfermedad.
Nuevas terapias con avances tecnológicos

Nuevas terapias con avances tecnológicos
Aunque aún no tiene cura, ya hay terapias que intentan frenar su progresión. Existe, por ejemplo, una plataforma web donde los profesionales que trabajan en la neurorrehabilitación pueden hacer tanto la evaluación de las funciones cognitivas de sus pacientes, cómo recursos para trabajar la estimulación cognitiva.
Con este tipo de herramientas, los enfermos de Parkinson con problemas en la velocidad de procesamiento o toma de decisiones encuentran soluciones mediante la repetición de ejercicios.






